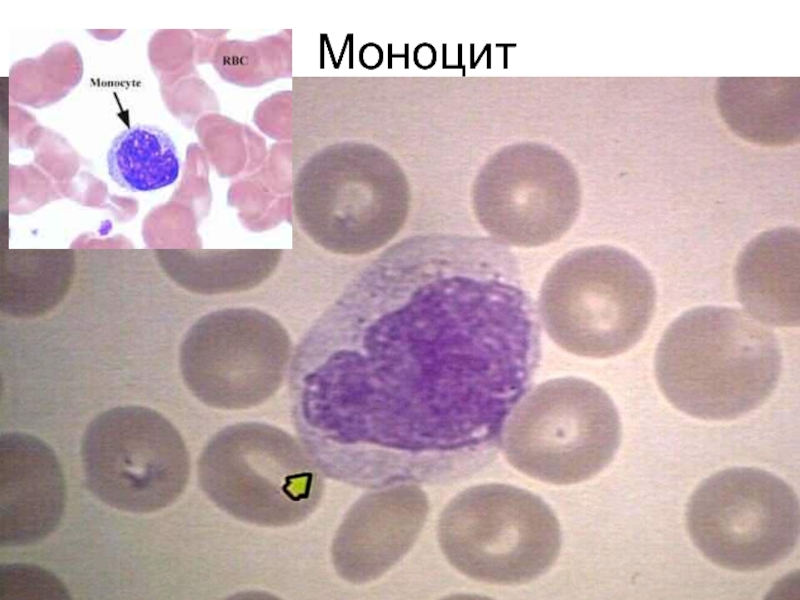

- Главная
- Разное
- Дизайн
- Бизнес и предпринимательство
- Аналитика
- Образование
- Развлечения
- Красота и здоровье
- Финансы
- Государство
- Путешествия
- Спорт
- Недвижимость
- Армия
- Графика
- Культурология
- Еда и кулинария
- Лингвистика
- Английский язык
- Астрономия
- Алгебра
- Биология
- География
- Детские презентации
- Информатика
- История
- Литература
- Маркетинг
- Математика
- Медицина
- Менеджмент
- Музыка
- МХК
- Немецкий язык
- ОБЖ
- Обществознание
- Окружающий мир
- Педагогика
- Русский язык
- Технология
- Физика
- Философия
- Химия
- Шаблоны, картинки для презентаций
- Экология
- Экономика
- Юриспруденция
Костномозговое кроветворение. Нормы крови. Схема кроветворения презентация
Содержание
- 1. Костномозговое кроветворение. Нормы крови. Схема кроветворения
- 2. схема кроветворения Согласно современной схеме, предложенной А.И.
- 3. Эритропоэз Эритроциты, или «красные кровяные тельца» (Red
- 4. ? Почему (за счет чего) форма эритроцитов двояковогнутая? Для чего эритроциту такая форма?
- 5. Ответы Основная функция эритроцитов — транспорт
- 6. схема кроветворения Согласно современной схеме, предложенной А.И.
- 7. Схема кроветворения И.Л.Черткова, Н.И.Дризе, А.И.Воробьева, 2006 г.
- 8. ЭРИТРОПОЭЗ Около 12 суток В процессе созревания
- 9. пронормоцит ЭРИТРОПОЭЗ
- 11. Ретикулоциты – молодые формы эритроцитов, в цитоплазме
- 12. Ретикулоциты Ретикулоциты, которые несколько крупнее эритроцитов, в
- 13. Регуляция эритропоэза 1. Эритропоэтины – физиологичские стимуляторы кроветворения,
- 14. Гемоглобин Дыхательный пигмент, сложный белок хромопротеид состоящий
- 15. Нормальные формы гемоглобина HbР – примитивный гемоглобин, содержит
- 16. Виды гемоглобинов В процессе онтогенеза меняются формы
- 17. Патологические формы гемоглобина HbS – гемоглобин серповидно-клеточной анемии. MetHb –
- 18. Нормальные показатели Hb Норма гемоглобина у женщин
- 19. Гематокрит Кровь на 40—45 % состоит из форменных элементов,
- 20. Норма эритроцитов Эритроциты у женщин
- 21. эритроцитоз Увеличение количества эритроцитов – эритроцитоз (эритремия):
- 22. эритропения Уменьшение количества эритроцитов – эритропения 1)
- 23. цветовой показатель При различных формах анемий содержание
- 25. средний объем эритроцитов Средний объем эритроцита (MCV
- 26. средний объем эритроцитов В сторону уменьшения (MCV
- 27. среднее содержание гемоглобина в эритроците Среднее содержание
- 28. Средняя концентрация гемоглобина в эритроците Средняя
- 29. ОАК, ХАРАКТЕРИСТИКИ КРАСНОГО РОСТКА Эритроцитарные индексы
- 30. СОЭ (ESR) – слой плазмы, освобождающийся от
- 31. Схема кроветворения И.Л.Черткова, Н.И.Дризе, А.И.Воробьева, 2006 г.
- 32. схема кроветворения Согласно современной схеме, предложенной А.И.
- 33. Схема кроветворения И.Л.Черткова, Н.И.Дризе, А.И.Воробьева, 2006 г.
- 34. НЕЙТРОФИЛОПОЭЗ Миелобласт нейтрофильный – 12-20 мкм, крупное
- 35. НЕЙТРОФИЛОПОЭЗ Палочкоядерные и сегментоядерные нейтрофилы могут находиться
- 37. Нейтрофил
- 38. ЭОЗИНОФИЛОПОЭЗ Эозинофилопоэз происходит в костном мозге и
- 39. Эозинофил
- 40. БАЗОФИЛОПОЭЗ Количество базофилов в периферической крови меньше,
- 41. Базофил
- 42. Нейтрофильная зернистость – розовато-фиолетовая, пылевидная,
- 44. Зернистые лейкоциты или гранулоциты характеризуются наличием
- 45. ОАК: ЛЕЙКОЦИТЫ - ГРАНУЛОЦИТЫ
- 46. МОНОЦИТОПОЭЗ Моноцитопоэз происходит в костном мозге и
- 47. Моноцит
- 48. Лимфоциты Лимфоциты — клетки иммунной системы, обеспечивают гуморальный иммунитет (выработка антител), клеточный
- 49. Схема кроветворения И.Л.Черткова, Н.И.Дризе, А.И.Воробьева, 2006 г.
- 50. ЛИМФОЦИТОПОЭЗ Лимфоцитопоэз в эмбриональном и постэмбриональном периодах
- 51. B-лимфоцитопоэз У человека и млекопитающих B-лимфоциты образуются и созревают в костном мозге и
- 52. Т-лимфоцитопоэз Незрелые Т-лимфоциты образуются в костном мозге, затем мигрируют в
- 53. Лимфоцит
- 56. СОСТАВ КРОВИ: ЛЕЙКОЦИТЫ - АГРАНУЛОЦИТЫ Лимфоциты характеризуются
- 57. ОАК: ЛЕЙКОЦИТЫ – АГРАНУЛОЦИТЫ И ТРОМБОЦИТЫ
- 58. Форменные элементы крови Тромбоциты (Platelets, PLT) —
- 59. Схема кроветворения И.Л.Черткова, Н.И.Дризе, А.И.Воробьева, 2006 г.
- 60. ТРОМБОЦИТОПОЭЗ Тромбоциты, участвующие в гемостатических реакциях, представляют
- 61. Мегакариоцит
Слайд 2схема кроветворения
Согласно современной схеме, предложенной А.И. Воробьевым и И.Л. Чертковым (1973),
I. Полипотентные стволовые кроветворные клетки (ГСК).
II. Полиолигопотентные коммитированные клетки-предшественницы.
III. Моноолигопотентные коммитированные клетки-предшественницы.
IV. Бласты.
V. Созревающие клетки.
VI. Зрелые клетки.
Слайд 3Эритропоэз
Эритроциты, или «красные кровяные тельца» (Red Blood Cells, RBC) — безъядерные
Нормальный размер эритроцита составляет 7,5–8,3 мкм; Эритроцит проходит через капилляры 2,5 – 3 мкм. Высокая способностью к деформации
продолжительность жизни — 90–120 дней. Разрушаются в селезенке
Цитоплазма эритроцита на 96% заполнена гемоглобином.
Слайд 5Ответы
Основная функция эритроцитов — транспорт дыхательных газов.
Безъядерность эритроцитов: газообмен (место
Двояковогнутая форма:большая площадь поверхности - быстрее поглощает кислород
Форма эритроцитов поддерживается благодаря стабилизирующему белку мембраны — спектрину
Слайд 6схема кроветворения
Согласно современной схеме, предложенной А.И. Воробьевым и И.Л. Чертковым (1973),
I. Полипотентные стволовые кроветворные клетки (ГСК).
II. Полиолигопотентные коммитированные клетки-предшественницы.
III. Моноолигопотентные коммитированные клетки-предшественницы.
IV. Бласты.
V. Созревающие клетки.
VI. Зрелые клетки.
Слайд 8ЭРИТРОПОЭЗ
Около 12 суток
В процессе созревания клеток эритроцитарного ростка изменяется их ряд
1. Уменьшаются размеры клетки;
2. Цитоплазматический матрикс увеличивается в количестве;
3. Окраска клетки меняется с голубой (базофильной) на розоватую, розовую и затем красную вследствие уменьшения содержания в клетке РНК и ДНК и накопления гемоглобина;
4. Уменьшаются размеры ядра клетки, причём в конце созревания оно не только уменьшается в размерах, но и становится характерно «сморщенным», а затем выталкивается из клетки, которая лишается ядра на стадии ретикулоцита;
5. У незрелых клеток эритроидного ряда ядро содержит открытый, рыхло упакованный хроматин, в процессе созревания хроматин становится всё более плотно упакованным, конденсированным.
Слайд 11Ретикулоциты – молодые формы эритроцитов, в цитоплазме которых, после потери ядра,
Слайд 12Ретикулоциты
Ретикулоциты, которые несколько крупнее эритроцитов, в течении 1-2 суток остаются в
Слайд 13Регуляция эритропоэза
1. Эритропоэтины – физиологичские стимуляторы кроветворения, вырабатываются разными тканями, но в
2. Продукты распада эритроцитов стимулируют выработку эритропоэтинов. Чем больше эритроцитов погибает, тем активнее кроветворение. При патологии (анемии, в том числе гемолитической) кроветворение столь активно, что костный мозга выбрасывает в кровь множество ретикулоцитов и ядерные формы проэритроцитов.
3. Гипоксия – кислородное голодание тканей – в любых её проявлениях увеличивает выработку эритропоэтинов, стимулируя кроветворение. Этим объясняется стойкое повышение ретикулоцитов в крови у жителей высокогорья, спортсменов, курильщиков.
4. Стресс может вызвать как повышение, так и снижение ретикулоцитов в крови.
5. Факторы Кастла – биоактивные вещества, выделяемые слизистой желудка (в большей степени) и кишечника, а также витамин В12 и фолиевая кислота. Они образуют активные комплексы с определёнными белками организма, попадают в печень, затем в костный мозг, стимулируя эритропоэз.
Слайд 14Гемоглобин
Дыхательный пигмент, сложный белок хромопротеид состоящий из 4 глобиновых цепей и
Гем – небелковая группа, протопорфириновое кольцо в центре которого заключен ион Fe.
Глобин – белковая часть молекулы гемоглобина состоящая из 2 пар полипептидных цепочек, которые различаются по аминокислотному составу и могут быть - α, β, γ, σ (дельта), ε (эпсилон), ξ (кси).
Слайд 15Нормальные формы гемоглобина
HbР – примитивный гемоглобин, содержит 2ξ- и 2ε-цепи, встречается в
HbF – фетальный гемоглобин, содержит 2α- и 2γ-цепи, появляется через 12 недель внутриутробного развития и является основным после 3 месяцев. Этот гемоглобин можно встретит в крови плода или новорожденного ребенка в первые несколько недель жизни. Это более активный в плане переноса кислорода гемоглобин, но быстро разрушающийся под воздействием факторов окружающей среды.
Дифинитивный (гемоглобин взрослого). HbA (HbA 1) – гемоглобин взрослых, доля составляет 98%, содержит 2α- и 2β-цепи, у плода появляется через 3 месяца жизни и к рождению составляет 80% всего гемоглобина,
HbA2 – гемоглобин взрослых, доля составляет 2%, содержит 2α- и 2δ-цепи,
HbO2 – оксигемоглобин, образуется при связывании кислорода в легких, в легочных венах его 94-98% от всего количества гемоглобина,
HbCO2 – карбогемоглобин, образуется при связывании углекислого газа в тканях, в венозной крови составляет 15-20% от всего количества гемоглобина.
Слайд 16Виды гемоглобинов
В процессе онтогенеза меняются формы гемоглобина: первоначально эмбрион имеет HbP
Фетальный вид гемоглобина — это белок крови у плода. Он активно соединяет и затем переносит кислород по сравнению с аналогичным веществом в организме взрослого человека. В связи с этим ребенок в утробе матери и ещё некоторое время после появления на свет может переносить периоды недостатка кислорода намного лучше по сравнению со старшими родственниками.
Слайд 17Патологические формы гемоглобина
HbS – гемоглобин серповидно-клеточной анемии.
MetHb – метгемоглобин, форма гемоглобина, включающая трехвалентный ион
Hb-CO – карбоксигемоглобин, образуется при наличии СО (угарный газ) во вдыхаемом воздухе. Он постоянно присутствует в крови в малых концентрациях, но его доля может колебаться от условий и образа жизни.
HbA1С – гликозилированный гемоглобин. Концентрация его нарастает при хронической гипергликемии.
Слайд 18Нормальные показатели Hb
Норма гемоглобина
у женщин 120 — 140 г/л.
у беременных женщин
Слайд 19Гематокрит
Кровь на 40—45 % состоит из форменных элементов, на 55—60 % из плазмы— жидкого межклеточного
Гематокрит (НСТ) – это соотношение объёмов форменных элементов и плазмы крови(в % или л/л).
У мужчин – 0,4 – 0,48,
у женщин 0,36 – 0,42.
Повышается гематокрит
у больных эритремией,
понижается – у больных анемией.
Слайд 20Норма эритроцитов
Эритроциты
у женщин 3,7-4,7*1012\л,
у мужчин – 4-5,1*1012\л,
что связано
Ретикулоциты в норме составляют 0,5-2% эритроцитов периферической крови.
Нормоциты в норме в периферической крови не определяются, их появление может свидетельствовать о внекостномозговом кроветворении или о патологии костномозгового кроветворения.
Слайд 21эритроцитоз
Увеличение количества эритроцитов – эритроцитоз (эритремия):
1) абсолютная, обусловленная продукцией эритроцитов (высокогорная
2) относительный (рабочий – сгущение крови при интенсивной мышечной деятельности, при усиленном потоотделении, при потере жидкости).
Слайд 22эритропения
Уменьшение количества эритроцитов – эритропения
1) абсолютная (преобладание процесса гемолиза над эритропоэзом
2) относительный (обусловлена избыточным количеством воды в сосудистом русле).
Слайд 23цветовой показатель
При различных формах анемий содержание Hb в эритроците неодинаково, поэтому
Цветовой показатель (ЦП) – относительная величина, среднее содержание Hb в эритроците
ЦП = 3х Hb (г/л)/первые 3 цифры содержания эритроцитов
Норма 0,9-1,1 (0,86-1,05)
Пример: гемоглобин 130 г/л, Er 4,70 х10^12/л
ЦП = 3х130/470 = 0,83
Слайд 25средний объем эритроцитов
Средний объем эритроцита (MCV – mean corpuscular volume) является
вычисляют путем деления гематокритной величины на общее количество эритроцитов в крови
MCV = гематокрит (%) х 10 / количество эритроцитов (1012/л)
Норма MCV – 75-95 мкм3
фемтолитрах (фл) . 1 фл = 1 мкм3.
Пример:
гематокрит - 40%, эритроциты – 4,5*1012/л.
MCV=4/4,5*109= 89 мкм3
Слайд 26средний объем эритроцитов
В сторону уменьшения (MCV в гематологическом анализаторе
В сторону увеличения (MCV>95/100 фл) – макроцитоз;
Размеры эритроцитов без изменений – нормоцитоз.
Слайд 27среднее содержание гемоглобина в эритроците
Среднее содержание Hb в эритроците (МСН) -
МСН = Hb (г/л)/ число эритроцитов (1012/л )
Норма 26,7 – 33,3 пг.
Пример: гемоглобин – 120 г/л, эритроциты – 4,12*1012л. МСН=120:4,12=29,1 пг
Слайд 28Средняя концентрация гемоглобина в эритроците
Средняя концентрация Hb в эритроците MCHC (Mean
Отражает степень насыщенности эритроцита гемоглобином
МСНС = Hb (г/л)/ гематокрит
Норма: 315-360 г/л
МСНС
Слайд 29ОАК, ХАРАКТЕРИСТИКИ КРАСНОГО РОСТКА
Эритроцитарные индексы (MCV, MCH, MCHC):
MCV (mean corpuscular volume)
Норма: 80—100 фл!!!
NB! В старых анализах указывали: микроцитоз (диаметр эритроцитов <7 мкм), нормоцитоз (d=7-9 мкм), макроцитоз (d=9-12 мкм), мегалоциты (d>12 мкм).
MCH (mean content hemoglobin) = HGB/RBC - среднее содержание гемоглобина в отдельном эритроците в абсолютных единицах
Норма: 26—34 пикограмм!!!
NB! В старых анализах указывали: Цветовой показатель = 3 × Hb в г/л / три Сейчас рассчитать цветовой показатель можно следующим образом: ЦП=MCH*0.03
MCHC (mean corpuscular hemoglobin concentration)— средняя концентрация гемоглобина в эритроцитарной массе, а не в цельной крови, отражает степень насыщения эритроцита гемоглобином.
Норма: норма 300—380 г/л
Анизоцитоз эритроцитов (RDW - Red cell Distribution Width), %
Норма: 11,5 - 14,5%
Анизоцитоз - наличие в крови форменных элементов (клеток), выходящих по размерам за пределы физиологической вариации (нормы).
Слайд 30СОЭ (ESR) – слой плазмы, освобождающийся от эритроцитов в течение 1
Норма: женщины 2-15 мм/час, мужчины 1-10 мм/час
Осмотическая резистентность эритроцитов – способность эритроцитов сопротивляться гемолизу.
Норма: от 0,52% (минимальная) до 0,32% (максимальная) – то есть гемолиз начинается в 0,52% NaCl, заканчивается - 0,32% NaCl.
ОАК, ХАРАКТЕРИСТИКИ КРАСНОГО РОСТКА
Слайд 32схема кроветворения
Согласно современной схеме, предложенной А.И. Воробьевым и И.Л. Чертковым (1973),
I. Полипотентные стволовые кроветворные клетки (ГСК).
II. Полиолигопотентные коммитированные клетки-предшественницы.
III. Моноолигопотентные коммитированные клетки-предшественницы.
IV. Бласты.
V. Созревающие клетки.
VI. Зрелые клетки.
Слайд 34НЕЙТРОФИЛОПОЭЗ
Миелобласт нейтрофильный – 12-20 мкм, крупное ядро округлой формы и узкий
Промиелоцит нейтрофильный – самая крупная 25 мкм, округлое ядро, базофильная цитоплазма с азурофильными гранулами
Миелоцит нейтрофильный – 12-20 мкм, округлое или овальное ядро, цитоплазма фиолетово-розовая с коричневатой зернистостью
Метамиелоцит нейтрофильный – 10-14 мкм, ядро палочкообразно согнуто, нейтрофильная окраска цитоплазмы
Палочкоядерный гранулоцит – компактное ядро разннобразной формы (подкова, жгут, буква S и др.), нейтрофильная цитоплазма с зернами
Сегментоядерный гранулоцит – ядро из нескольких сегментов, соединенных тонкими нитями
Миелобласт и промиелоцит делятся один раз, миелоцит - два раза. После этого клетки созревают без деления.
Продолжительность нейтрофилопоэза - 6-10 дней. Регуляция продукции нейтрофилов осуществляется сложной системой стимуляторов (ИЛ3, ГМ-КСФ, Г-КСФ и т.д.) и ингибиторов гранулоцитопоэза, которые вырабатываются премущественно макрофагами, моноцитами и нейтрофилами.
Слайд 35НЕЙТРОФИЛОПОЭЗ
Палочкоядерные и сегментоядерные нейтрофилы могут находиться в костном мозге до 4
В норме примерно 90% всех нейтрофилов находится в костном мозге, 2-3% в периферической крови и 7-8% - в тканях. Примерно половину нейтрофилов периферической крови составляют циркулирующие клетки, а вторую половину - нейтрофилы пристеночного (маргинального) пула, это неподвижностоящие клетки.
Таким образом, в анализе крови мы определяет 1-1.5% всех нейтрофилов организма.
В ответ на хемотактические стимулы из тканей (С5а, лейкотриен В4 и пр.) часть часть циркулирующих нейтрофилов может переходить в пристеночный пул. В периферической крови нейтрофилы находятся в среднем 6-10 часов, а затем попадают в ткани, где существуют 1-4 дня.
Слайд 38ЭОЗИНОФИЛОПОЭЗ
Эозинофилопоэз происходит в костном мозге и во многом сходен с нейтрофилопоэзом.
Помимо ИЛ3 и ГМ-КСФ в регуляции эозинофилопоэза принимает участие ИЛ5. Предшественники до эозинофильного миелоцита неотличимы от нейтрофильных.
Продожительность пребывания эозинофилов в крови - до 15 часов.
Продолжительность жизни эозинофилов в тканях (кожа, желудочно-кишечный тракт, соединительная ткань) значительно больше, чем у нейтрофилов, кроме этого они способны переходить из тканей в кровеносное русло. В крови находится менее 1% всех эозинофилов организма.
Основными функциями эозинофила являются участие в аллергических реакциях, противопаразитарная защита организма и удаление фибрина, возникшего в ходе воспалительных процессов.
Слайд 40БАЗОФИЛОПОЭЗ
Количество базофилов в периферической крови меньше, чем других клеток.
Отличительным признаком
Базофилы и тучные клетки имеют на поверхности рецепторы к иммуноглобулину Е. Основная функция базофилов и тучных клеток - участие в аллергических и воспалительных реакциях.
Слайд 42
Нейтрофильная зернистость – розовато-фиолетовая, пылевидная, обильная, неравномерная;
Эозинофильная зернистость – кирпично-розового или
Базофильная зернистость – фиолетового или черного цвета, неоднородная, необильная, располагается на ядре и цитоплазме.
Слайд 44Зернистые лейкоциты или гранулоциты
характеризуются наличием в цитоплазме специфической зернистости и
Нейтрофилы в периферической крови определяются в виде сегментоядерных форм, которые имеют ядра, состоящие из 2-3 и более долек, и палочкоядерных форм, которые имеют ядра в виде изогнутой палочки (подковы, буквы S).
60 % нейтрофилов находится в костном мозге, 40 % – в легких, печени, селезенке, желудочно-кишечном тракте, мышцах, почках, 1 % – в периферической крови.
Продолжительность жизни нейтрофилов 4-5 дней.
Стимуляторами гранулопоэза и мобилизации их из депо являются: бактериальная инфекция, АКТГ, гидрокортизон, пирогенал, некоторые вакцины, ультрафиолетовое облучение, метаболиты раковой опухоли.
Основные функции: бактерицидная, вирусоцидная, дезинтоксикационная, кандидоцидная обусловлены фагоцитарной активностью нейтрофилов и большим количеством гидролитических и других ферментов; участвуют в воспалительных процессах благодаря биологически активным веществам (энзимной и неэнзимной природы); ведущая роль в образовании активных эндогенных пирогенов и формировании лихорадочной реакции; принимают участие в жизнедеятельности соединительной ткани; участвуют в фибринолизе; обладают тромбопластической активностью.
Эозинофилы – более крупные клетки, чем нейтрофилы, диаметр составляет 12-14 мкм, в цитоплазме содержат специфические оксифильные гранулы, в которых находятся гидролитические ферменты.
Продолжительность жизни в тканях составляет 8-12 дней.
Основные функции: принимают участие в защитных реакциях организма на чужеродный белок; участвуют в реакции гиперчувствительности немедленного типа, инактивируют гистамин с помощью фермента гистаминазы; участвуют в реакции гиперчувствительности замедленного типа); способны к фагоцитозу.
Базофилы имеют диаметр около 11-12 мкм. Цитоплазма базофилов содержит крупные, округлые или полигональные базофильные гранулы, в которых находятся гепарин, гистамин, серотонин, пероксидаза, кислая фосфатаза.
Продолжительность жизни базофилов 8-12 дней, время циркуляции в периферической крови несколько часов.
Базофилы содержат на своей поверхности специальные рецепторы для антител класса иммуноглобулин Е.
Основные функции: принимают участие в регуляции процессов свертывания крови и проницаемости сосудов, выделяя гепарин и гистамин; участвуют в иммунологических реакциях организма, присоединяя иммуноглобулин Е, регулируют комплекс антиген-антитело; участвуют в реакциях гиперчувствительности немедленного и замедленного типов.
Слайд 46МОНОЦИТОПОЭЗ
Моноцитопоэз происходит в костном мозге и во многом сходен с нейтрофилопоэзом.
В моноцитопоэзе выделяют несколько морфологически различаемых стадий: монобласт, промоноцит и моноцит.
Регуляция его осуществляется с помощью факторов роста и ингибиторов (ИЛ3, ГМ-КСФ, М-КСФ и т.д.).
В отличие от нейтрофилов, у моноцитов нет крупного костномозгового резерва.
Среднее время пребывания моноцитов в крови - 8-16 часов. Моноциты, попадая в ткани, дифференцируются в макрофаги, которые могут обладать специальными функциями в зависимости от локализации тканей (в частности макрофаги могут уничтожать опухолевые клетки). Продолжительность пребывания макрофагов в тканях - до нескольких лет.
Слайд 48Лимфоциты
Лимфоциты — клетки иммунной системы, обеспечивают гуморальный иммунитет (выработка антител), клеточный иммунитет (контактное взаимодействие с клетками-жертвами), а
В организме взрослого человека 25-40% всех лейкоцитов крови составляют лимфоциты (500-1500 клеток в 1 мкл), у детей доля этих клеток равна 50%.
ЛИМФОЦИТОПОЭЗ
ЛИМФОЦИТОПОЭЗ
Слайд 50ЛИМФОЦИТОПОЭЗ
Лимфоцитопоэз в эмбриональном и постэмбриональном периодах протекает поэтапно, сменяя собой различные
Лимфоцитопоэз подразделяется на: T-лимфоцитопоэз и B-лимфоцитопоэз.
В свою очередь, каждый из них разделяет на три этапа: костномозговой этап; этап антигеннезависимой дифференцировки, осуществляемый в центральных иммунных органах; этап антигензависимой дифференцировки, осуществляемый в периферических лимфоидных органах.
Особенностью лимфоцитопоэза является способность дифференцированных клеток (лимфоцитов) дифференцироваться в бластные формы.
Слайд 51B-лимфоцитопоэз
У человека и млекопитающих B-лимфоциты образуются и созревают в костном мозге и затем заканчивают своё созревание в селезёнке и лимфатических
Образовавшиеся в костном мозгу и в селезёнке B-лимфоциты затем покидают костный мозг и селезёнку и мигрируют в периферические лимфоидные ткани, такие, как лимфатические узлы.
Оказавшись в лимфатическом узле или в другом вторичном лимфоидном органе, B-лимфоцит может быть «представлен» тому или иному антигену, который он способен распознать (или, вернее, антиген представлен, презентирован ему). Иначе говоря, В-лимфоцит может быть «ознакомлен» с антигеном. Этот «ознакомительный» процесс происходит благодаря помощи макрофагов, моноцитов, гистиоцитов или дендритных клеток, при посредническом участии Т-лимфоцитов-хелперов. Все эти клетки обладают способностью захватывать (фагоцитировать), «перерабатывать» (процессировать) и «представлять» (презентировать) различные антигены B- и T-лимфоцитам в форме, удобной для распознавания ими, вместе с поверхностными антигенами гистосовместимости (MHC). Поэтому они (макрофаги, моноциты, гистиоциты и дендритные клетки) совокупно называются «антиген-презентирующими клетками».
В-клетка превращается в иммунобласт и пролиферирует, производя много копий клеток, распознающих антиген
Слайд 52Т-лимфоцитопоэз
Незрелые Т-лимфоциты образуются в костном мозге, затем мигрируют в корковый слой тимуса, где становятся так
По окончании недели не более 2-4 % изначальной популяции кортикальных тимоцитов выживает. Оставшиеся 96-98 %, не прошедшие селекцию, «приговариваются к смертной казни» соседями, подвергаются апоптозу и затем фагоцитируются макрофагами тимуса. Столь большой процент гибели кортикальных тимоцитов в процессе созревания обусловлена чрезвычайно жёстким отбором и интенсивным скринингом на всех этапах созревания. Этот отбор должен обеспечить, чтобы каждый кортикальный тимоцит (будущий Т-лимфоцит) обладал способностью распознавать антигены главного комплекса гистосовместимости своего организма как «свои» и обладал врождённой иммунологической толерантностью к «своим» здоровым клеткам и тканям. Не прошедший отбора и подвергнувшийся апоптозу кортикальный тимоцит погибает и быстро утилизируется макрофагами тимуса. Таким образом, этот отбор в норме исключает появление аутоагрессивных Т-лимфоцитов, агрессию Т-лимфоцитов против собственных здоровых клеток и тканей и развитие аутоиммунных заболеваний.
Затем Т-лимфоциты выходят в кровоток, при распознавании антигена активируются, превращаются в Т-иммунобласт и пролиферируют в лимфоидных тканях, затем снова выходят в кровоток (создается «армия клонов»)
Слайд 56СОСТАВ КРОВИ: ЛЕЙКОЦИТЫ - АГРАНУЛОЦИТЫ
Лимфоциты характеризуются наличием интенсивно окрашенного ядра округлой
В-лимфоциты:
Обеспечение гуморального иммунитета благодаря выработке гуморальных медиаторов (лимфокинов)
Образующиеся из В-лимфоцитов эффекторные клетки – плазмоциты вырабатывают особые защитные белки – иммуноглобулины (IgM, IgG, IgA, IgE, IgD).
Тимусзависимые лимфоциты (Т-лимфоциты) обеспечивают реакции клеточного иммунитета и регуляцию гуморального иммунитета:
Цитотоксические Т-лимфоциты (киллеры), которые являются эффекторными клетками клеточного иммунитета, убивают чужие и собственные измененные клетки;
Т-лимфоциты- хелперы (помощники), обладают способностью специфически распознавать антиген и усиливать образование антител
Т-супрессоры (угнетающие), подавляющие способность В-лимфоцитов участвовать в выработке антител.
Моноциты – крупные клетки крови, размер их достигает 18-20 мкм. Ядра моноцитов – бобовидные, дольчатые, подковообразные.
осуществляют фагоцитоз чужеродных частиц, макромолекул, коллагена, клеток крови и гемоглобина, выполняя в организме роль ―мусорщиков;
агоцитоз возбудителя, иммунных комплексов, продуктов клеточного распада;
выделение биологически активных веществ (простагландинов), ферментов;
взаимодействие с плазменными (свертывающей, фибринолитической и кининовой системами) и тканевыми факторами;
образование активных пирогенов;
выделение ингибиторов воспаления;
участвуют в реализации иммунного ответа.
Слайд 58Форменные элементы крови
Тромбоциты (Platelets, PLT) — «кровяные пластинки», или
частицы отшнуровавшейся цитоплазмы
Тромбоциты обладают свойствами адгезии (прилипания), агрегации (склеивания).
Они содержат биологически активные вещества, определяющие их участие в механизмах свертывания крови и фибринолиза, в обеспечении ангиотрофической функции.
! Они не являются истинными
клетками, хотя приравниваются
к таковым.
Размер тромбоцитов — 1–2 мкм.
Продолжительность жизни 8 суток.
Слайд 60ТРОМБОЦИТОПОЭЗ
Тромбоциты, участвующие в гемостатических реакциях, представляют собой фрагменты цитоплазмы мегакариоцитов дискоидной
Мегакариоциты - очень крупные клетки с характерным полиплоидным ядром, которые легко определяются при микроскопии костного мозга. В ходе созревания клеток мегакариоцитарного ряда важное место занимает процесс эндорепликации ДНК, в результате которого возникают полиплоидные мегакариоциты. Плоидность мегакариоцитов может варьировать от 4N до 32N.
В зависимости от зрелости принято выделять мегакарибласты, промегакариоциты и мегакариоциты. По мере дифференцировки плоидность клеток возрастает.
Регуляция мегакариоцитопоэза осуществляется с помощью стимуляторов и ингибиторов. Стимулирующим эффектом обладают мегакариоцитарный колониестимулирующий фактор, ГМ-КСФ, ИЛ3 и ИЛ6. Процесс дифференцировки мегакариоцитов и образования тромбоцитов регулируется с помощью тромбопоэтина.